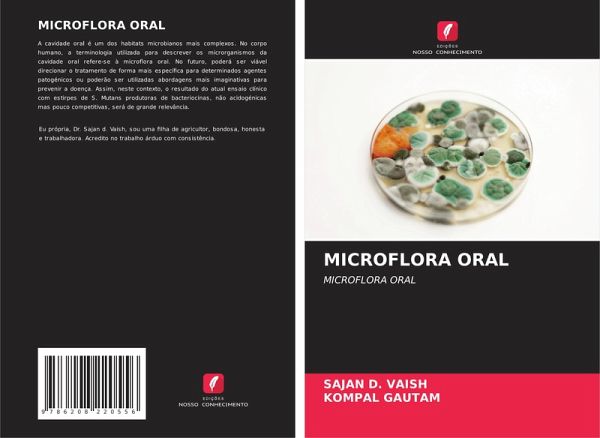
MICROFLORA ORAL

MICROFLORA ORAL
MICROFLORA ORAL
Versandkostenfrei!
Versandfertig in 6-10 Tagen
39,99 €
inkl. MwSt.
PAYBACK Punkte
20 °P sammeln!
A cavidade oral é um dos habitats microbianos mais complexos. No corpo humano, a terminologia utilizada para descrever os microrganismos da cavidade oral refere-se à microflora oral. No futuro, poderá ser viável direcionar o tratamento de forma mais específica para determinados agentes patogénicos ou poderão ser utilizadas abordagens mais imaginativas para prevenir a doença. Assim, neste contexto, o resultado do atual ensaio clínico com estirpes de S. Mutans produtoras de bacteriocinas, não acidogénicas mas pouco competitivas, será de grande relevância.